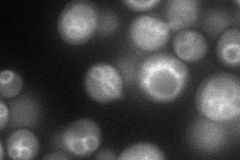
YLL029W
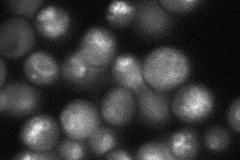
YLL029W

View description
Protein involved in negative regulation of transcription of iron regulon; forms an iron independent complex with Fra2p, Grx3p, and Grx4p; cytosolic; mutant fails to repress transcription of iron regulon and is defective in spore formation
Localization:
Intensity:
Fold change:
Significance:
-
C’ GFP library in SD

cytosol67.2 -
N' NOP1pr-GFP in SD
vacuole membrane64.1919 -
N' TEF2pr-mCherry in SD

below threshold82.18 -
N' NATIVEpr-GFP in SD
vacuole membrane56.1956 -
N' TEF2pr-VC and Cyto-VN in SD

#N/A0 -
C’ GFP library in SD+DTT

cytosolN/AN/ANo -
C’ GFP library in SD+H2O2

cytosolN/AN/ANo -
C’ GFP library in Starvation Media

nucleusN/AN/AYes -
C’ GFP library on the background of Pup2-DaMP

cytosol -
C’ GFP library on the background of CCT mutant

cytosolN/AN/ANo
